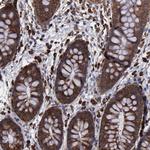
RPS4X Antibody in Immunohistochemistry (Paraffin) (IHC (P))

Search
Invitrogen
RPS4X Polyclonal Antibody
{{$productOrderCtrl.translations['antibody.pdp.commerceCard.promotion.promotions']}}
{{$productOrderCtrl.translations['antibody.pdp.commerceCard.promotion.viewpromo']}}
{{$productOrderCtrl.translations['antibody.pdp.commerceCard.promotion.promocode']}}: {{promo.promoCode}} {{promo.promoTitle}} {{promo.promoDescription}}. {{$productOrderCtrl.translations['antibody.pdp.commerceCard.promotion.learnmore']}}
产品信息
PA5-51468
种属反应
宿主/亚型
分类
类型
抗原
偶联物
形式
浓度
纯化类型
保存液
内含物
保存条件
运输条件
RRID
产品详细信息
Immunogen sequence: KVRKITVGVK GIPHLVTHDA RTIRYPDPVI KVNDTVQIDL GTGKIINFIK FDTGNLCMVI GGANLGRVGV ITNRERHPGS FDVVHVKDAN GNSFATRLSN IFVIGNGNKP WISLPRGKGI RLTVA
Highest antigen sequence identity to the following orthologs: Mouse - 91%, Rat - 91%.
靶标信息
Ribosomes, the organelles that catalyze protein synthesis, are composed of a small subunit (40S) and a large subunit (60S) that consist of over 80 distinct ribosomal proteins. Mammalian ribosomal proteins are encoded by multigene families that contain processed pseudogenes and one functional intron-containing gene within their coding regions. RPS4Y2 (ribosomal protein S4, Y-linked 2), RPS4Y1 (ribosomal protein S4, Y-linked 1) and RPS4X (ribosomal protein S4, X-linked) are proteins that contain one S4 RNA-binding domain and exist as components of the 40S ribosomal subunit, indicating a possible role in protein synthesis.
仅用于科研。不用于诊断过程。未经明确授权不得转售。
篇参考文献 (0)
生物信息学
蛋白别名: 40S ribosomal protein S4; cell cycle gene 2; ribosomal protein S4X isoform; SCR10; Single copy abundant mRNA protein; single-copy abundant mRNA; Small ribosomal subunit protein eS4, X isoform
基因别名: CCG2; DXS306; RPS4; RPS4X; S4; SCAR; SCR10
UniProt ID: (Human) P62701
Entrez Gene ID: (Human) 6191